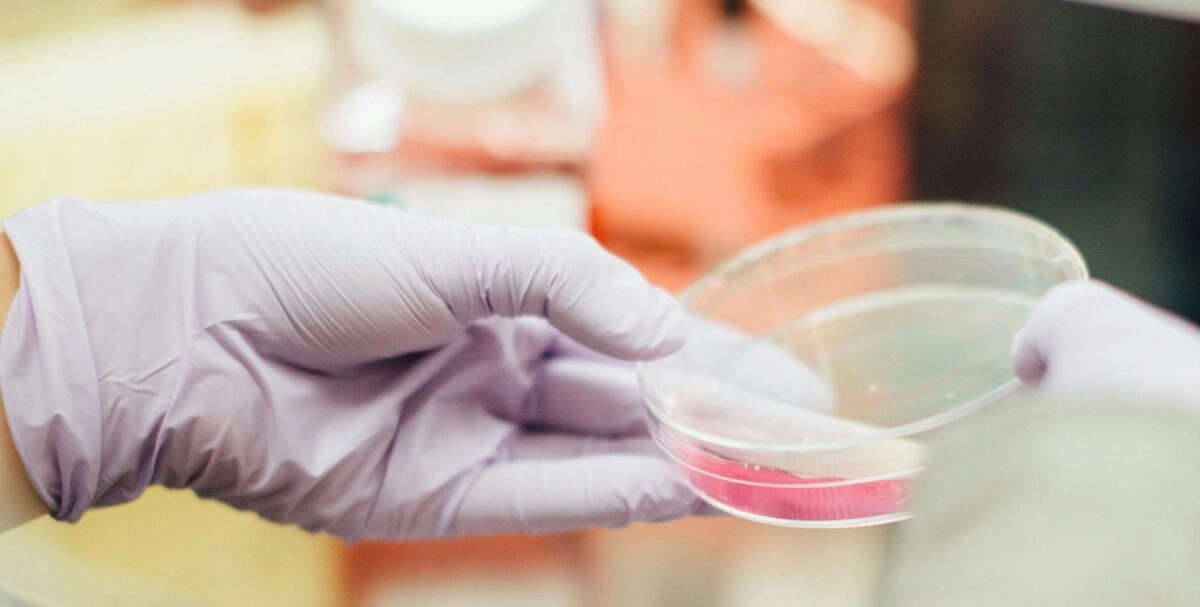
Ιατρικές εξετάσεις

Σε δύο νέα εγχειρήματα στον τομέα της υγείας αναφέρθηκε ο Κυριάκος Μητσοτάκης στην εβδομαδιαία του ανασκόπηση. Πρόκειται για την έναρξη λειτουργίας για νέους δικαιούχους του προγράμματος «Φώφη Γεννηματά», το οποίο πραγματοποιεί δωρεάν εξετάσεις μαστού στις δικαιούχες γυναίκες, προκειμένου να υπάρχει έγκαιρη αντιμετώπιση του καρκίνου του μαστού. Επιπλέον, ο Πρωθυπουργός ενημέρωσε για την νέα ηλεκτρονική πλατφόρμα μέσω της οποίας μπορούν να πραγματοποιηθούν δωρεάν αιματολογικές εξετάσεις στις δημοτικές δομές. Αναλυτικά ο Κυριάκος Μητσοτάκης ανέφερε,
«Έρχομαι στον χώρο της υγείας. Σας έχω μιλήσει αρκετές φορές γι’ αυτό, αλλά σήμερα είναι σημαντικό να πούμε ότι μέσα στην εβδομάδα ξεκίνησε η αποστολή των SMS στις νέες δικαιούχους του Εθνικού Προγράμματος για την Πρόληψη του Καρκίνου του Μαστού «Φώφη Γεννηματά». Οι νέες ηλικιακές ομάδες είναι γυναίκες 45-49 και 70-74 ετών, δηλαδή σχεδόν 567.000 γυναίκες, ενώ το πρόγραμμα συνολικά αφορά 1,4 εκατομμύρια γυναίκες. Όσες δεν έχετε ενεργοποιήσει την άυλη συνταγογράφηση, μπορείτε να απευθυνθείτε σε οποιοδήποτε συνεργαζόμενο κέντρο, δημόσιο ή ιδιωτικό, για να κλείσετε το ραντεβού σας χωρίς καμία οικονομική επιβάρυνση. Να θυμίσω ότι μέχρι στιγμής έχουν γίνει πάνω από 300.000 μαστογραφίες και έχουν εντοπιστεί έγκαιρα με συμπτώματα πάνω από 20.000 γυναίκες, κάτι που δίνει πολύ μεγάλες πιθανότητες για την πλήρη ίασή τους. Αν λάβετε μήνυμα λοιπόν, μην το αγνοήσετε!
Μένω στον χώρο της υγείας για να θυμίσω ότι πλέον υπάρχει και η νέα ηλεκτρονική υπηρεσία για τον προγραμματισμό ραντεβού για δωρεάν Αιματολογικές Εξετάσεις στις Δημόσιες Δομές Παροχής Υπηρεσιών Πρωτοβάθμιας Φροντίδας Υγείας. Δηλαδή μπορείτε να επισκεφτείτε τη διαδικτυακή πλατφόρμα www.finddoctors.gov.gr, και να αναζητήσετε και να επιλέξετε την κατάλληλη δομή και την ημερομηνία που σας εξυπηρετεί στην περιοχή σας. Έτσι, και οι πολίτες θα εξυπηρετούνται χωρίς αναμονή και ταλαιπωρία και οι δομές πρωτοβάθμιας φροντίδας θα μπορούν να προσφέρουν καλύτερες υπηρεσίες.».